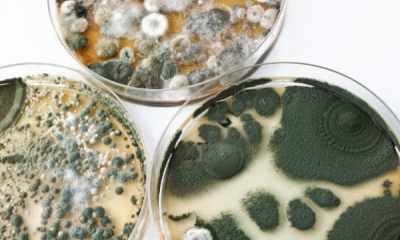
foto1339-2

Formas y técnicas efectivas sobre cómo eliminar fácilmente el moho de las paredes de su apartamento
 La placa de hongos en las paredes de las habitaciones a menudo no es un problema grave.
La placa de hongos en las paredes de las habitaciones a menudo no es un problema grave.
Mientras tanto, el moho estropea no solo el aspecto estético de la casa, sino que también provoca un grave mal funcionamiento del cuerpo.
Para mantener sus reparaciones y su propia salud, es importante saber cómo deshacerse de los hongos dañinos de una vez por todas.
En este artículo te contamos como quitar el moho en un apartamento o en una casa con sus propias manos.
Contenido
Tipos de hongos
Las habitaciones mal ventiladas con mucha humedad entran en la zona de riesgo... El hongo puede desarrollarse en cualquier tipo de habitación, desde baño y terminando con una sala de estar. El moho afecta no solo a las paredes, sino también a los suelos, techo, artículos para el hogar.
Hay varios tipos de moho:
-
Verde... A menudo se puede ver en materiales de construcción naturales en bruto.
Verde... A menudo se puede ver en materiales de construcción naturales en bruto.El hongo verde oscuro crece en la superficie de los líquidos.
A menudo se encuentra en las paredes de la cocina, donde se forma condensación debido a la mala ventilación y la cocción prolongada.
- Blanco... Esta variedad casi no es agresiva, pero ocasionalmente causa alergias graves. Muy a menudo, el desarrollo comienza en los sótanos.
Afecta al suelo de las plantas de interior y, gracias a las esporas especialmente volátiles, pasa rápidamente a Marcos de ventana, paredes.
- Azul... La vista se puede observar en las paredes de madera (vigas, troncos, revestimiento). Dicho moho no es dañino para la salud, pero es peligroso porque incluso destruye el barniz y otros revestimientos protectores.
- Negro... El tipo de hongo más peligroso y tóxico. Puede aparecer en cualquier superficie, incluido el hormigón, fondo de pantalla.
Cómo y cómo puede eliminar el hongo con sus propias manos se discutirá a continuación.
Métodos tradicionales para uso doméstico.
 Existen varios remedios caseros eficaces para controlar el moho.
Existen varios remedios caseros eficaces para controlar el moho.
Remedios más populares:
- vinagre,
- peróxido,
- detergente de ropa,
Pero también se utilizan otros métodos populares.
¿Cómo eliminar con vinagre de mesa al 9%?
A veces se aconseja diluir el ácido acético con agua en una proporción de 80 a 20, pero para obtener el máximo efecto, es mejor no hacer esto, usándolo en su forma pura:
- El líquido se aplica a la pared con una pistola especial.
- Luego se deja durante 3-4 horas.
- Los restos se lavan con un paño húmedo.
Peróxido de hidrógeno
Incluso las colonias impresionantes del hongo no resistirán este líquido:
- La sustancia se usa sin diluir, se aplica con una botella de spray.
- Vuelva a aplicar después de 20 minutos.
- Fija el resultado con aceite esencial de árbol de té para mantener el efecto durante mucho tiempo.
Bura
Por sus propiedades insecticidas y herbicidas, la sustancia destruye con éxito los hongos en las paredes e incluso en los muebles tapizados:
- Se requiere preparar una solución de 1 cucharada de bórax con 3 litros de agua.
- Luego aplique sobre la zona afectada con una esponja.
- Después de manipularlo, limpie el exceso de líquido con un paño suave y seco.
- El bórax no necesita ser lavado, por lo que puede proteger contra los hongos durante mucho tiempo después de la aplicación.
Detergente de ropa
 El remedio es eficaz si el moho está empezando a crecer. No tiene efecto contra grandes colonias.
El remedio es eficaz si el moho está empezando a crecer. No tiene efecto contra grandes colonias.
Es importante utilizar jabón de lavar real con un contenido de ácidos grasos de al menos el 72%:
- Para su aplicación, el jabón se ralla y se diluye con agua tibia.
- Luego se tratan las paredes, lavando la composición después de unas horas.
Amoníaco
Para superficies duras y lisas (baldosas, vidrio), el amoníaco es muy adecuado:
- Para el procesamiento, el alcohol se mezcla con agua tibia (no caliente) por la mitad.
- Es mejor aplicar por analogía con vinagre (usando una botella de spray).
- Para que la solución funcione mejor, debe dejarse en la pared durante al menos 5 horas.
Bicarbonato de sodio (sosa)
 Una sustancia inofensiva y a la vez eficaz en la lucha contra cualquier moho.
Una sustancia inofensiva y a la vez eficaz en la lucha contra cualquier moho.
Para hacer una solución para el procesamiento, necesitará:
- una cucharada de bicarbonato de sodio
- vaso de agua.
Es más conveniente aplicar la solución con una esponja para platos y enjuagar no antes de las 4 horas.
Blanqueador (blanco)
Es importante que la composición contenga cloro activo, es él quien tiene un efecto perjudicial sobre el hongo. La sustancia se diluye con agua en una proporción de 2 a 5 y luego se aplica al molde.
El blanqueador de cloro no es adecuado para superficies coloreadas porque destruye:
- capa superior,
- pintar.
Se usa solo en áreas ventiladas, sin olvidar los guantes.
Cómo deshacerse del moho en la pared con blancura:
Sulfato de cobre
El sulfato de cobre sigue siendo el remedio más eficaz en la lucha contra el moho negro agresivo.
Para eliminar el hongo necesitará:
 sulfato de cobre - 0,1 kg;
sulfato de cobre - 0,1 kg;- 1 litro de agua a temperatura ambiente;
- recipiente grande esmaltado.
Puede agregar vinagre para mejorar el efecto.... Todos los ingredientes se diluyen y luego se aplican a las paredes.
Cuando use una solución de vitriolo, no se debe descuidar el equipo de protección personal, debe usar:
- guantes,
- respirador,
- gafas y ropa de tela gruesa.
La composición debe lavarse después de 2-3 horas.
El envenenamiento por la sustancia es poco común, pero ocurre cuando el tratamiento se realiza en interiores o si se ingiere accidentalmente.
Las 3 mejores herramientas especializadas
En los estantes de las ferreterías se pueden encontrar antisépticos eficaces que pueden matar hongos.... Se presentan:
- en latas de aerosol,
- latas
- botellas de spray.
El uso de cualquier producto antimoho especializado en las paredes solo es posible con el estricto cumplimiento de las instrucciones.
Molde de parada Olympus
Remedio popular permitido para uso en interiores... Los dueños de mascotas no tienen que preocuparse, la composición no es peligrosa.
La sustancia se usa para tratar superficies de:
- ladrillos
- madera,
- Roca,
- Paredes cubiertas con pintura y yeso.
Precio medio: no más de 400 rublos por 5 litros.... La herramienta también se presenta en una botella de 1 litro por valor de poco más de 100 rublos.

Dali
Un antiséptico universal que puede usarse en cualquier superficie. Se consume de forma económica gracias a un frasco con boquilla spray, se absorbe perfectamente.
A pesar de que el producto no contiene cloro, se recomienda usarlo solo en áreas bien ventiladas debido a su olor acre. Un bote con un volumen de 6 litros cuesta 580 rublos, una botella de 0,6 litros - 170 rublos.

Alpa Fongifluid
Antiséptico, que ya está diluido. Es eficaz tanto para tratamientos en interiores como en exteriores. Utilizar en el cálculo de 1 litro por 5 metros cuadrados. El precio de una lata de dos litros es de unos 600 r.

¿Cómo hacer reparaciones en la zona afectada?
Antes de proceder con la reparación en la habitación afectada por el hongo, debe sacar todos los muebles, usar un respirador y guantes. Entonces:
- Necesitas limpiar bien las paredes. Se quita el papel tapiz viejo, el yeso mohoso se limpia al concreto con una herramienta adecuada.
- El polvo residual se lava.
- Todas las paredes de la habitación se tratan con un antiséptico ("Biotol-Spray", "Mavix Bio", "Dali") de acuerdo con las instrucciones, luego se lavan y se secan. Es mejor dejar la superficie por un día para que no quede un exceso de humedad.
La pintura se lleva a cabo en varias etapas.: primero poner la primera capa, que se deja secar por completo. La segunda y las siguientes capas se aplican según el mismo principio.
Prevención de la aparición
Para evitar que el hongo se multiplique, debe asegurarse de que se cumplan una serie de condiciones:
 Control de humedad. El rango más adecuado es del 45 al 60%.
Control de humedad. El rango más adecuado es del 45 al 60%.- La cocina necesita una campana de alta calidad. Con la ebullición prolongada de líquidos, es necesario eliminar el condensado de las paredes a tiempo, asegúrese de que la humedad no exceda la norma permitida.
- El baño debe estar seco. Después de los procedimientos de agua, la puerta del baño debe dejarse abierta, de esta manera el aire circulará mejor. Un toallero eléctrico adicionalmente instalado puede proporcionar humedad y temperatura del aire normales en el baño.
- La violación de la tecnología para instalar ventanas de plástico conduce a la aparición de condensación. Debe eliminarse a tiempo, de lo contrario, crecerá rápidamente una colonia de moho, que luego se moverá a las paredes.
- Las grietas en el exterior de la casa pueden provocar la congelación de las paredes. Si este es el caso, el moho comienza a multiplicarse en lugares característicos: esquinas y juntas. No se olvide de las uniones entre las baldosas y otros huecos, comprobando periódicamente su estado.
- No debes secar la ropa directamente en la habitación, y más aún, poner la secadora cerca de la pared. Es necesario mantener la temperatura óptima del aire: no menos de 18, no más de 25 grados.
Conclusión
Los remedios caseros contra el moho en las paredes son bastante efectivos, pero las formulaciones especializadas muestran los mejores resultados.
El procesamiento debe realizarse lo antes posible, y en caso de daños importantes en las paredes, es mejor buscar ayuda de trabajadores profesionales de empresas de limpieza.


